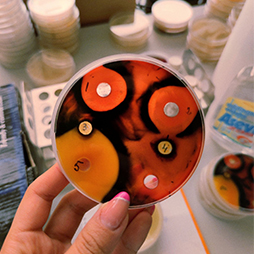

| Section 1 - Agronomy |
| Section 2 - Horticulture |
Miscellaneous
There are expected and accepted papers focused on subjects that represent the scientific basis of Horticulture
Climate-resilient horticulture; Ecological horticulture systems; Permaculture; Urban horticulture; Waste management and alternative energies in horticulture; New horticultural plants and crops.
| Section 3 - Animal Science |
Technologies of the agro food products processing
There are expected and accepted papers focused on subjects that represent the scientific basis of Animal Sciences
Cereals and oil processing; Livestock products processing; Fruit and vegetable processing; Traditional food processing; Food processing machinery; Preservation and Logistics; Agro-products quality and bio-safety.
| Section 4 - Veterinary Medicine |
Fundamental sciences
There are expected and accepted papers focused on the foundational scientific principles that underpin veterinary medicine, including anatomy, biochemistry and molecular biology, genetics, histology, cell biology, embryology, physiology, physiopathology, pharmacology, toxicology, microbiology, immunology, and molecular sciences as they relate to animal health..
Experimental Medicine
There are expected and accepted papers dedicated to research in experimental treatments, innovative therapies, and emerging technologies in veterinary medicine, as well as laboratory animala, animal models, translational medicine, ethics on animal experimentation, with a focus on advancing medical knowledge and techniques.
| Section 5 - Land Reclamation, Earth Observation & Surveying, Environmental Engineering |
Environmental science and engineering
There are expected and accepted papers focused on subjects that represent the scientific basis of Land Reclamation, Earth Observation & Surveying, Environmental Engineering
Pollution control and remediation; Resource management and sustainability; Climate change mitigation and adaptation; Environmental impact assessment; Renewable energy and sustainable technologies; Ecological restoration and conservation.
Miscellaneous
There are expected and accepted papers focused on subjects that represent the scientific basis of Land Reclamation, Earth Observation & Surveying, Environmental Engineering
Complementary topics; Novel research findings or methodologies that are still in their early stages or bridge multiple established fields; Interdisciplinary projects that combine knowledge and expertise from different disciplines to address complex challenges; Case studies that showcase unique applications or solutions to real-world problems; Emerging trends and technologies that have the potential to disrupt or transform the field; Artificial Intelligence; Big data.
| Section 6 - Biotechnology |
Agricultural Biotechnology
There are expected and accepted papers focused on subjects that represent the scientific basis of Biotechnology
Plant cell culture, bioproducts in plant protection, biostimulators, edible and medicinal mushrooms, GMO and risk assessment, genomics, proteomics, metabolomics, molecular markers.
| Section 7 - Management and Economics in Rural Areas |
Production economics and agromarketing
There are expected and accepted papers focused on subjects that represent the scientific basis of Management and Economics in Rural Areas
Agrifood economy; Financial economic analysis; The economic efficiency of agricultural production; Accounting; Qualitative and Quantitative Marketing; Marketing Strategies, Agromarketing.
Agritourism and rural tourism
There are expected and accepted papers focused on subjects that represent the scientific basis of Management and Economics in Rural Areas
Rural Development; Rural Sociology; Public food services and agrotourism; Agrotourism; Agrotouristic resource management; Touristic landscape planning; Rural tourism; Rural creative tourism.









 Soil sciences
Soil sciences Crop sciences
Crop sciences Miscellaneous
Miscellaneous Fruit growing
Fruit growing Viticulture and Oenology
Viticulture and Oenology Vegetable growing
Vegetable growing Floriculture, Ornamental Plants, Design and Landscape Architecture
Floriculture, Ornamental Plants, Design and Landscape Architecture Miscellaneous
Miscellaneous Genetics and breeding
Genetics and breeding Nutrition
Nutrition Reproduction, physiology, anatomy
Reproduction, physiology, anatomy Technologies of animal husbandry
Technologies of animal husbandry Technologies of the agro food products processing
Technologies of the agro food products processing Wild life management, fishery and aquaculture
Wild life management, fishery and aquaculture Miscellaneous
Miscellaneous Fundamental sciences
Fundamental sciences Clinical sciences
Clinical sciences Animal production, public health and food quality control
Animal production, public health and food quality control Veterinary education
Veterinary education Experimental Medicine
Experimental Medicine Miscellaneous
Miscellaneous Environmental science and engineering
Environmental science and engineering Disaster resilience and sustainable development
Disaster resilience and sustainable development Water resources management
Water resources management Remote sensing and geoinformatics
Remote sensing and geoinformatics Miscellaneous
Miscellaneous Agricultural Biotechnology
Agricultural Biotechnology Food Biotechnology
Food Biotechnology Medical and Pharmaceutical Biotechnology
Medical and Pharmaceutical Biotechnology Environmental Biotechnology
Environmental Biotechnology Miscellaneous
Miscellaneous Production economics and agromarketing
Production economics and agromarketing Farm and cooperatives management
Farm and cooperatives management Agricultural and rural policies
Agricultural and rural policies Environmental economics and bioeconomy
Environmental economics and bioeconomy Digital economy and innovation in modern agriculture and food chain
Digital economy and innovation in modern agriculture and food chain Miscellaneous
Miscellaneous